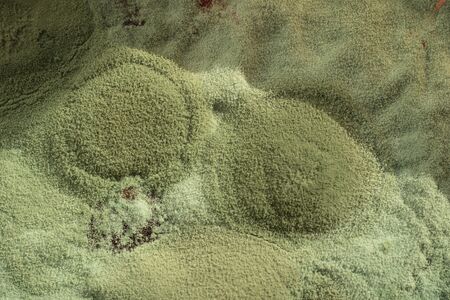
Green mold on food close macro backgroundの写真素材

写真素材 - Green mold on food close macro background
キーワード
- abstract
- backdrop
- background
- biology
- biotechnology
- black
- cement
- closeup
- concrete
- damp
- decay
- design
- detail
- dirty
- food
- fungal
- fungus
- green
- growth
- grunge
- health
- illness
- infection
- life
- macro
- material
- medicine
- microbiology
- mildew
- mold
- moldy
- mycelium
- natural
- nature
- old
- organic
- pattern
- petri
- plant
- rotten
- rough
- spoiled
- spores
- structure
- surface
- texture
- unhealthy
- wall
- wallpaper
- white
類似作品
Mold close-up m...
Green mold on f...
Mold growing on...
Mushroom cultiv...
Wedge of soft b...
Closeup to Tric...
Mold, rotting f...
Close up of mol...
A rotten apple ...
Old rotten cucu...
Mold close-up m...
Fungi culture o...
blue and white ...
cherry jelly wi...
Mould aka mold ...
Closeup bread m...
Orange moldy ri...
moldy bread clo...
Old rotten cucu...
Mold close-up m...
blue mold backg...
close-up of a d...
Close up of mol...
Closeup to Tric...
Macro photo of ...
mold isolated o...
Moulded bread o...
Various types o...
fungal mildew o...
Rotten, spoiled...
Texture of the ...
mold on juice, ...
Mold on bread o...
macro, pumpkin ...
Dry old stump i...
moldy cheese pi...
Real powerful g...
Abstract closeu...
spoiled canned ...
Abstract green ...
Modern biotechn...
Bright kitchen ...
Mold and fungus...
The image displ...
A piece of food...
Two slices of s...
moldy bread
Moldy yogurt co...
Penicillium, as...